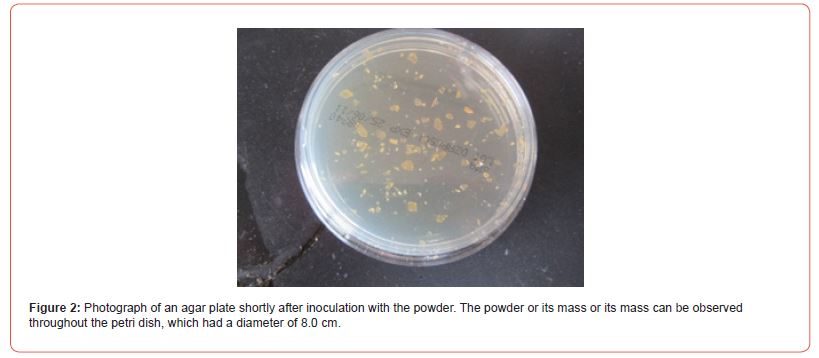
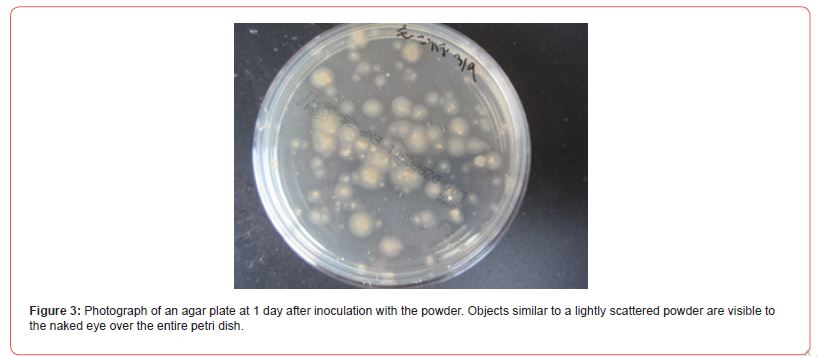
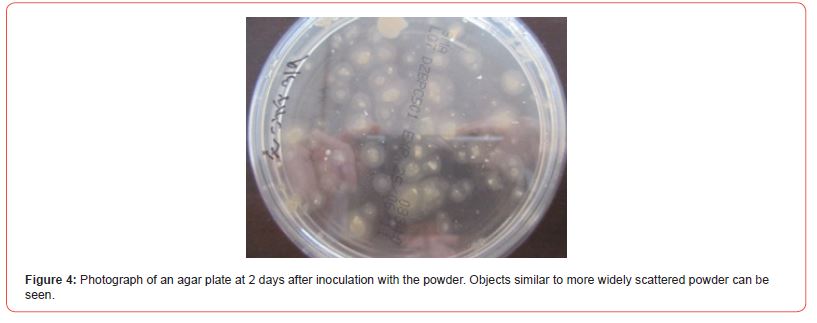
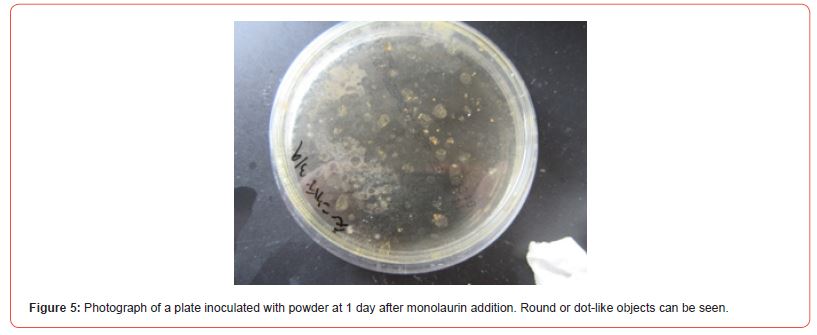
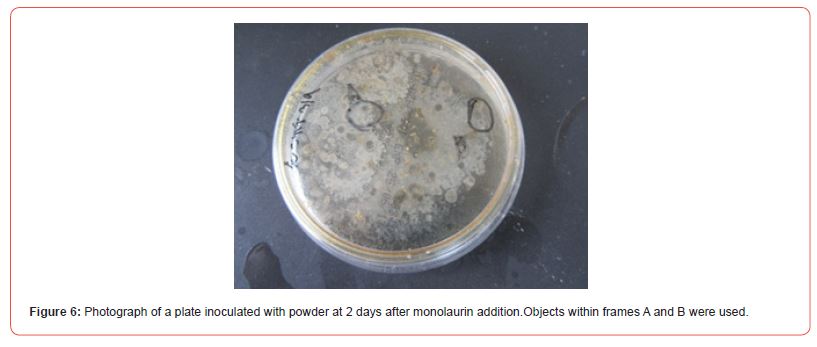
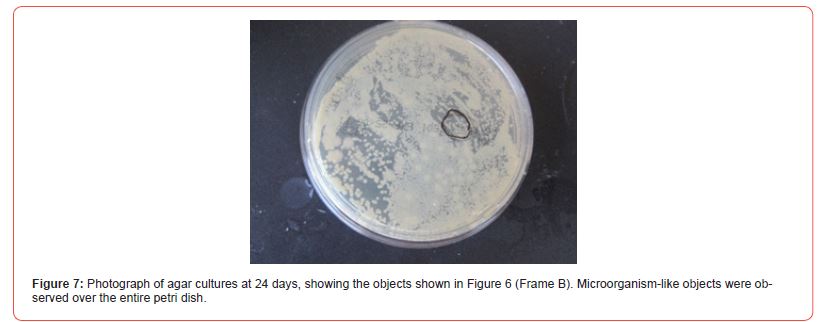
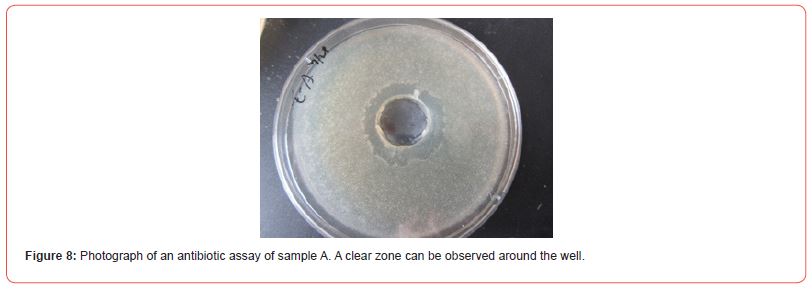
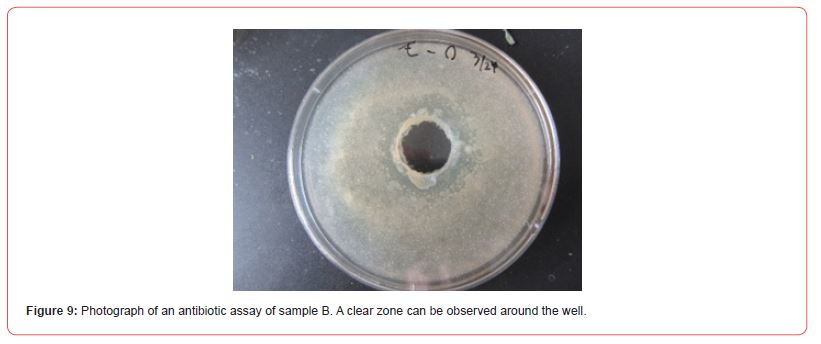

Research Article
Antibiotic-Producing Cells Produced from A Plate Culture of Egg Powder Enclosing DNA (Nannochloropsis Species
Shoshi Inooka, Japan Association of Science Specialists, Japan
Received Date: April 28, 2025; Published Date: May 05, 2025
Abstract
DNA crown cells can be prepared using sphingosine (Sph)-DNA-adenosine-monolaurin compounds cultured in egg white. Numerous types of DNA crown cells have been prepared to date. Recently, several studies have described the antibiotic-producing cells with DNA crown cells and partners. To increase the potential value of these antibiotic-producing cells, the present study examined whether antibiotics or antibiotic-producing cells were produced using DNA (Nannochloropsis species) and yeast. The results showed that antibiotic-producing DNA (Nannochloropsis) crown cells could be produced in combination with yeast. The resulting cells were named antibiotic-producing crown-Nannochloropsis-yeast cells.
Keywords: DNA (Nannochloropsis) crown cells, Sphingosine-DNA, antibiotic-producing crown-Nannochloropsis-yeast cells, monolaurin
Introduction
Self-replicating artificial cells were first produced in 2012 [1] using methods reported in 2016 [2]. These cells, the exterior of which consists of DNA, were designated DNA crown cells in 2016 by the present author [3]. DNA crown cells can be produced using four commercially available compounds: sphingosine (Sph), DNA, adenosine, and monolaurin and by incubation in egg white. Numerous kinds of DNA crown cells have been produced to date [4–8], and different strains of these cells have been prepared by the author [9–14].
DNA crown cells have several promising applications in biotechnology and medicine.
For example, these cells can be used to produce antibiotics or antibiotic- producing cells [15-19]. Consequently, DNA crown cells are expected to be useful in the medical field. On the other hand, if value-added antibiotic-producing cells could be separated, then the perceived value of DNA crown cells would increase in numerous fields, especially in the medical field. In the present experiments, it was examined whether value-added antibiotic-producing cells could be separated from the egg white powder used to enclose DNA (Nannochloropsis) crown cells in the presence of yeast. In addition, future studies will examined whether such cells have any value-added functions. The developed cells were named antibiotic- producing crown-Nannochloropsis-yeast cells.
Materials and Methods
Materials
DNA (Nannochloropsis) crown cells were prepared as described previously and refrigerated at approximately 4°C [7]. However, the methods are provided here again.
The materials used were the same as those employed in previous studies [7,19,20]: Sph (Tokyo Kasei, Japan), DNA (from Nannochloropsis species), adenosine (Sigma-Aldrich; Wako, Japan), and monolaurin (Tokyo Kasei), which were combined to prepare adenosine- monolaurin (A-M). The monolaurin solution was prepared to a final concentration of 0.1 M in distilled water. Agar plates were prepared using standard agar medium (SAM) (AS ONE, Japan). Potato dextrose agar (PDA; Kyodo Nyugiou, Tokyo, Japan), Bacillus subtilis (Daikokuya, Nagoya, Japan), Dulbecco’s modified eagle’s medium (DMEM; Sigma, USA), and bovine serum (Sigma) were also used.
Methods
Preparation of DNA (Nannochloropsis) crown cells [7, 20,21]
a. Step 1: A total of 180 μl of Sph (10 mM) and 90 μL of DNA (0.32 μg/μl) were combined, and the mixture was heated and cooled twice.
b. Step 2: A-M solution (100 μl) was added and the mixture was incubated at 37°C for 15 min.
c. Step 3: A total of 100 μl of monolaurin solution was added, and the mixture was incubated at 37°C for another 5 min.
d. Step 4: The whole suspension (approximately 300 μl) was injected into egg white and incubated for 7 days at 37°C. The egg white was then recovered and used as DNA (Nannochloropsis) crown cells.
Preparation of powder
a. First, 3 ml distilled water containing yeast (10 mg/ml) was mixed with 3 ml of egg white.
b. Mixtures were incubated for 5 h at 37°C.
c. Approximately 25 ml of fresh egg white was then added to the mixture.
d. The supernatant was poured and spread onto two petri dishes, which were incubated to dryness at 37°C for 1–2 days.
e. The dried materials were then collected and ground into a powder with a mortar and pestle.
f. The powder, referred to as crown-Nannochloropsis-yeast-P, was stored at room temperature before use (Figure 1).

Preparation of sample to assay antibiotics
A small amount of powder (30–40 mg) was added to an agar plate and incubated for 2 days at 37°C. Then, approximately 1.5 ml of 0.1 M monolaurin solution was poured onto the plate, which was then incubated for 2 days at 37°C. The objects (Figure 6, frame A) that formed after the addition of monolaurin were re-suspended in a small volume of distilled water (about 0.4 ml) and an aliquot of this solution (200 μl) was then added to 5 ml of DMEM containing 10% bovine serum and incubated at 37°C for 2–7 days. The culture fluids were used as the sample (A) for the antibiotic assays.
Objects (Figure 6; frame B) were suspended in a small quantity of distilled water (about 0.4 ml), and 200 μl of distilled water was poured onto an agar plate and incubated at 37°C for 1–2 days.
Cultured objects (Figure 7, within the frame) were then collected and placed in a small quantity of distilled water (about 0.4 ml). This solution was used to inoculate 5 ml of DMEM containing 10% bovine serum and incubated at 37°C for 2–5 days (Figure 7; objects comprised of Sample B are shown within the frame). Samples A and B were then tested for antibiotics.
Preparation of plates for measuring antibiotic production
The antibody assay was carried out using an agar-well method, as described previously [16]. Briefly, the test bacterium (Bacillus subtilis) was mixed with 200 ml agar medium and poured into petri dishes. A well measuring approximately 2 cm in diameter was then prepared in each plate. The test fluid (approximately 400 μl) was dispensed into the well of each plate, and the plates were incubated for 18 h at 37°C. After incubation, a zone of inhibition was observed.
General observations
Objects on plates were observed by the naked eye.
Results
Figure 2 shows a photograph of an agar plate shortly after culturing the powder. Powder or its mass were observed throughout the petri dish, which had a diameter of 8.0 cm.
Figure 3 shows a photograph of an agar plate at 1 day after culture using the powder. Objects similar to a lightly scattered powder were visible to the naked eye over the entire petri dish.
Figure 4 shows a photograph of an agar plate at 2 days after culturing with the powder. Objects similar to more widely scattered powder was observed.

Figure 5 shows a photograph of a plate with powder at 1 day after monolaurin addition. Round or dot-like objects were observed.
Figure 6 shows a photograph of a plate inoculated with powder at 2 days after monolaurin addition. Objects within the frame A were cultured on DMEM containing 10% bovine serum, while objects within the frame B were cultured on an agar plate. Growing objects were used as sample B.

Figure 7 shows a photograph of agar cultures at 24 days, showing the objects shown in Fig. 6 (Frame B). Microorganism-like objects were observed over the entire petri dish. Some of the objects (within the frame) were cultured with DMEM containing 10% bovine serum and used for the antibiotic assay (Sample B).
Figure 8 shows a photograph of an antibiotic assay of sample A. A clear zone was observed around the well.
Figure 9 shows a photograph of an antibiotic assay of sample B. A clear zone was observed around the well.

DNA crown cells have several promising applications in biotechnology and medicine.
Recently, methods for producing antibiotic-producing DNA crown cells have been described by the present author [15-19]. Such antibiotic-producing cells may have value added and increase the potential applications of DNA crown cells. Here, as a first step, it was examined whether value-added antibiotic-producing cells could be separated using DNA (Nannochloropsis) crown cells. Using the same methods described previously [15], antibiotic-producing cells were separated from the culture fluids of egg white powders which enclosed DNA (Nannochloropsis) crown cells with yeast.
On the other hand, here, yeast was used as a partner for DNA crown cells. In previous experiments, it was demonstrated that tissue extracts or cells were effective as a partner [15-19]. Many living or non-living materials could be used as a partner, implying that an unlimited number of new organisms with antibiotic-producing characteristics or cells with other functions (i.e., value-added functions) could potentially be created with DNA crown cells and their partners. In this study, antibiotic-producing cells generated under the influence of DNA (Nannochloropsis) crown cells may obtain information from Nannochloropsis. These new organisms could potentially contribute to the production of energy, fish meal, and environmental restoration (e.g., the degradation of pollutants).
Conclusion
In conclusion, the methods for producing antibiotics and antibiotic-producing cells with DNA (Nannochloropsis) crown cells and yeast as a partner were described. Future studies should examine whether these antibiotic-producing cells have other valueadded functions, such as anti-Bacillus antibiotics, which could potentially benefit human welfare. Using the nomenclature system described previously [16], the cells developed in this study are named antibiotic-producing crown-Nannochloropsis-yeast cells p, i.e., antibiotic-producing DNA (Nannochloropsis) Crown cells with yeast, where P indicates powder derived from egg white (culture source). The antibiotic produced in this study is the sixth such finding, and so it is named crown antibiotic-8.
References
- Inooka S (2012) Preparation and cultivation of artificial cells. App Cell Biol 25(6): 13-18.
- Inooka S (2016) Preparation of Artificial Cells Using Eggs with Sphingosine-DNA. J Chem Eng Process Technol 7(1): 277-281.
- Inooka S (2016) Aggregation of sphingosine-DNA and cell construction using components from egg white. Integrative Molecular Medicine 3(6): 1-5.
- Inooka S (2017) Systematic Preparation of Bovine meat DNA Crown Cells. App Cell Biol Japan 30(2): 13-16.
- Inooka S (2013) Preparation of Artificial Cells for Yogut Production. App Cell Biol 26(8): 13-17.
- Inooka S (2014) Preparation of Artificial Placental Cells. App Cell Biol 27(6): 4-49.
- Inooka S (2019) Preparation of DNA (Nannochloropsis species) crown cells (artificial cells) using eggs, sphingoshin, and DNA, and subsequent cell recovery. App Cell Biol 32(4): 55-64.
- Inooka S (2018) Systematic Preparation of Generated DNA (Akoya pear oyster) Crown Cells. App Cell Biol Japan 31(5): 21-34.
- Inooka S (2022) Preparation of a DNA ( coli) Crown Cell line in Vitro-Microscopic Appearance of Cells. Annals of Reviews and Research 8(1): 555728- 555734.
- Inooka S (2023) Preparation and Microscopic Appearance of a DNA (Human Placenta) Crown Cell Line. Journal of Biotechnology & Bioresearch 5(1): 655-658.
- Inooka S (2023) Preparation of a DNA (Akoya pearl oyster) crown cell line. Applied Cell Biology Japan 36(1): 1-5.
- Inooka S (2022) Microscopic appearance of synthetic DNA ( coli) crown cells in primary culture. App Cell Biol Japan 35(9): 71-98.
- Inooka S (2022) Microscopic Appearance of Synthetic DNA ( coli) Crown Cells in Secondary Cultures. Novel Research in Science 12(4): 01-06.
- Inooka S (2023) Preparation of a DNA (Hepatoblastoma-Derived Cell line: HepG2) Crown Cell line. Journal of Tumor Medicine & Prevence 4(2): 01-06.
- Inooka S (2025) Isolation of Antibiotic Producing Cells from Plate Culture of Egg Powder Enclosing DNA (Bovine Meat) Crown Cells and Beef Extract. Annals of Reviews and Research 12(5): 01-08.
- Inooka S (2025) Separation of Antibiotic-Producing Cells from Beer Produced in Co-cultures of DNA (Streptomyces) Crown Cells with Yeast. Annals of Reviews and Research 12(3): 01-07.
- Inooka S (2025) Separation of antibiotic producing cells from culture fluids of egg white powder enclosed DNA(Streptomyces) crown cells and yeast. International Journal of Bioprocess & Biotechnological Advancements 10(1): 499-504.
- Inooka S (2025) Separation of Antibiotic-Producing Cells from Agar Cultures of Egg Powder-Enclosed DNA (hepato-blastoma cell Line:HepG2) Crown Cell and Yeast. American Journal of Biomedical Science & Research 26(2): 01-06.
- Inooka S (2025) Isolation of Antibiotic-Producing Cells from Cultures of Egg Cultures of Egg Powder Enclosing DNA (Hepg2) Crown Cells and Salmon Roe. Trends in General Medicine 3(1):1-5.
- Inooka S (2017) Biotechnical and Systematic Preparation of Artificial Cells (DNA Crown Cells). The Global Journal of Research in Engineering 17(1): 1-11.
- Inooka S (2017) Systematic Preparation of Artificial Cells (DNA Crown Cells). J Chem Eng Process Technol 8(1): 327-331.
-
Shoshi Inooka*. Antibiotic-Producing Cells Produced from A Plate Culture of Egg Powder Enclosing DNA (Nannochloropsis Species) Crown Cells and Yeast. Sci J Biol & Life Sci. 4(2): 2025. SJBLS.MS.ID.000582.
-
DNA (Nannochloropsis) crown cells, Sphingosine-DNA, antibiotic-producing crown-Nannochloropsis-yeast cells, monolaurin
-

This work is licensed under a Creative Commons Attribution-NonCommercial 4.0 International License.






